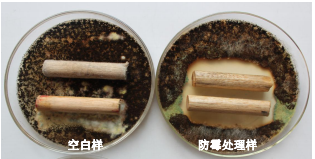
1668816816999.png image.png

概述
竹防二号主要用于竹材、木材的防霉,可为制品提供良好且持久的防霉性能。竹防二号是一种高效、广谱、耐热 的防霉剂,其化学性能稳定,不含重金属,符合欧盟 RoHS 指令要求,适用于各种竹木制品。
适用范围
◎木质包装类:如酒盒、珠宝盒、化妆品盒等。
◎建材类:如地板、栅栏、吊顶板、壁板、木屋等。
◎装饰材料类:如相框、搁板、工艺品等。
◎家具类:如衣柜、床、沙发、桌椅、鞋柜等。
◎其他类:如游艇甲板、音箱、竹根雕、木雕等。
使用方法
1.使用前,请戴橡胶手套和口罩。
2.配制粉体防霉浸泡液:将防霉剂按照比例 0.5%-1%或 1:200-1:100 用开水稀释配制,搅拌 5-10min 至均匀。
3.将需要处理的材料放入盛有防霉浸泡液的池中,浸泡 20min-10h 即可捞出,根据材料、工厂情况,决定浸泡时间和
比例。若浸泡时间短,建议用高比例。浸泡 5 次后,可补充 0.1%。
4.自然晾干或者烘干,即可实现长时间防霉。
温馨提示
1.使用时勿接触到眼睛或鼻子,以免造成皮肤接触过敏,操作过程中请佩戴口罩和手套。
2.初次使用请根据产品的颜色、气味等是否符合要求进行加工工艺测试。
使用效果
-
环保木材防霉剂
 点击收藏 查看详情
点击收藏 查看详情 -
油漆防霉抗菌剂
 点击收藏 查看详情
点击收藏 查看详情 -
防霉喷剂
 点击收藏 查看详情
点击收藏 查看详情 -
纺织防霉抗菌剂
 点击收藏 查看详情
点击收藏 查看详情 -
皮革防霉抗菌剂
 点击收藏 查看详情
点击收藏 查看详情 -
涂料防霉剂(分散体)
 点击收藏 查看详情
点击收藏 查看详情
























































